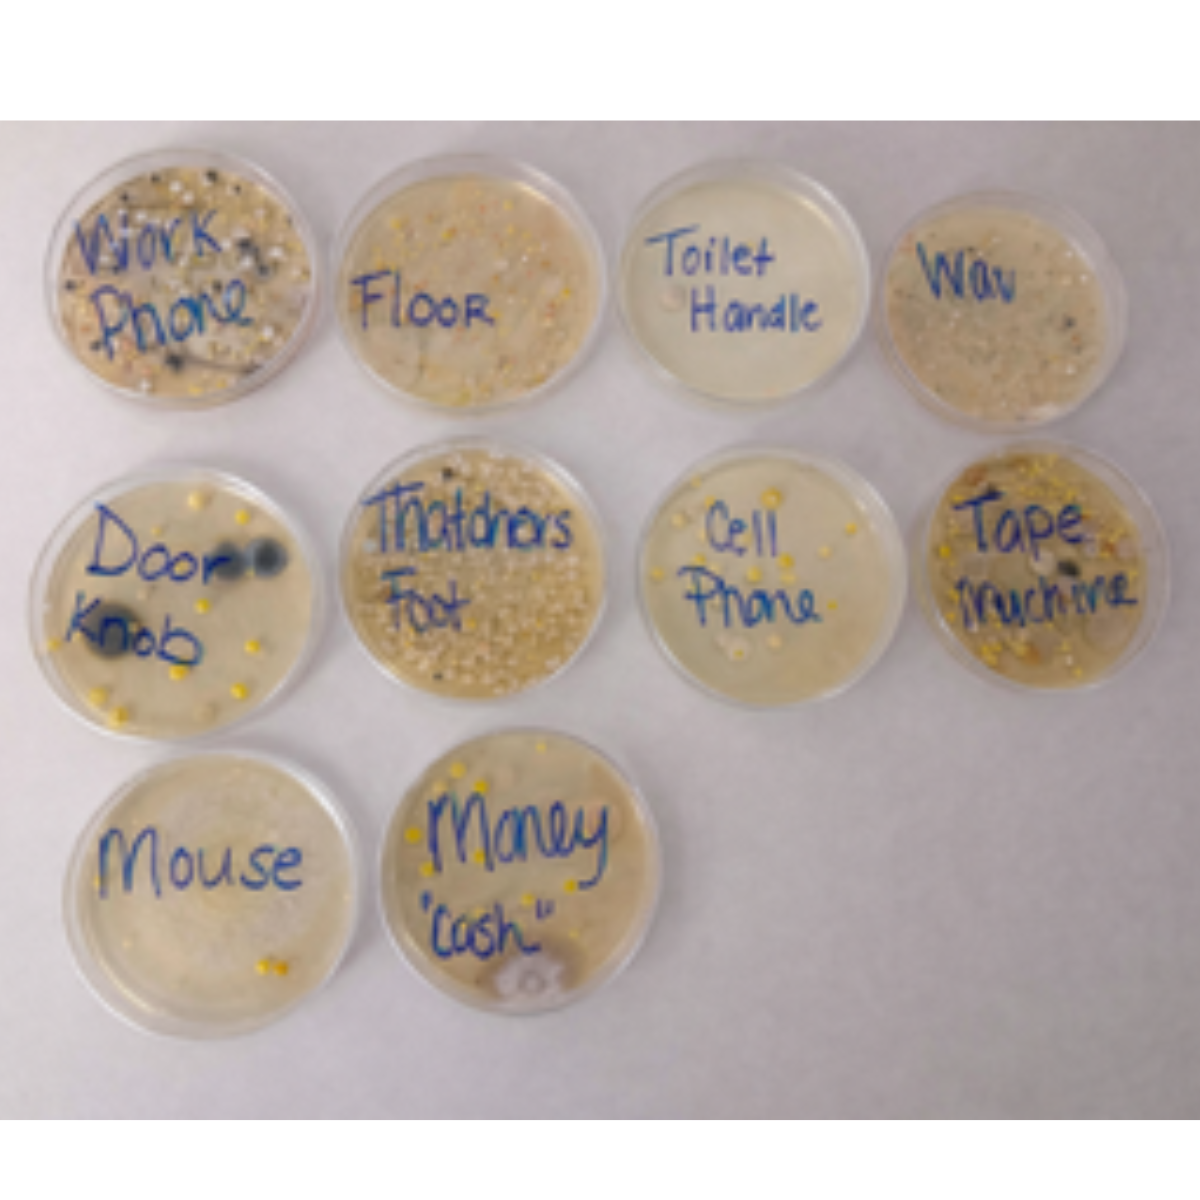

Germ Experiment
A Books By the Bushel Germ Experiment

Our Interactive Learning Experience includes:
· FREE activities to download!
· A book to go along with the activities or to read for fun
· Pictures to go along with the process of the experiment

We did an in-house experiment here at Books By the Bushel.

Out of these listed, which would you think would have the most germs?
A. Work Phone
B. Thatcher, the Warehouse Cats' Foot
C. Tape Machine
D. Warehouse Order Pulling Vehicle
E. Floor
Out of these listed, which would you think would have the least amount of germs?
A. Cell Phone
B. Computer Mouse
C. Door Knob
D. Toilet Handle
E. Cash











